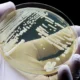
Süper Dirençli Mantar: Avrupa ve Avusturya’da Hızla Yayılıyor

Bu kış grip dalgası alışılmadık şekilde erken başladı – ve uzmanlar, geçtiğimiz yıllara kıyasla daha şiddetli olabileceğinden endişe ediyor. Uluslararası alanda vaka sayılarındaki artış bildirilirken, Avusturya olası zorlu bir sezona odaklanıyor. Bunun nedeni, Influenza-A virüsü H3N2’nin dikkat çekici şekilde değişmiş bir varyantı: sözde Subklade K.
Avrupa’daki sağlık otoriteleri haftalardır artan vaka sayılarını kaydediyor. Örneğin, Avrupa Hastalık Önleme ve Kontrol Merkezi (ECDC), grip teşhislerinin normal yıllara göre daha erken arttığını gözlemliyor. Avrupa Sağlık Kurumu ECDC’de Solunum Yolu Virüsleri Bölüm Başkanı Edoardo Colzani, alışılmadık derecede güçlü bir mevsimsel başlangıcın gözlemlendiğine işaret etti ve risk gruplarına erken aşı olma çağrısında bulundu.
Mevcut gelişmelerin merkezinde H3N2 virüsünün Subklade K’sı bulunuyor. Uzmanlar, bu virüs türünün kısa sürede çok sayıda mutasyon biriktirdiği konusunda uyarıyor. Leibniz Viroloji Enstitüsü’nden virolog Gülşah Gabriel, “Süddeutsche Zeitung”a yaptığı açıklamada, H3N2’nin şu anda diğer Influenza-A türlerine karşı baskın gelişiyor gibi göründüğünü ifade etti.
Buna ek olarak, bu türün daha sık alt solunum yollarını etkilediği ve bu nedenle daha fazla zatürreye yol açtığı belirtiliyor. 2022/23 grip sezonunun ağır geçmesi de H3N2’nin hakimiyeti altında olmuştu.
Güney yarımküre ülkelerine bir göz atmak, yetkilileri alarm durumuna geçiriyor. Avustralya, 400.000’den fazla laboratuvarca doğrulanmış vaka ile son sezonda tarihi bir rekor kaydetti. Tüm vakaların yaklaşık üçte biri 15 yaşın altındaki çocuk ve gençleri etkiledi. Güney yarımküredeki gelişmeler, genellikle Avrupa’nın habercisi olarak kabul ediliyor.
Subklade K şimdiden birkaç Avrupa ülkesinde hakim durumda. İngiltere’de grip sezonu normalden yaklaşık beş hafta erken başladı. Uzmanlara göre virüs, normal yıllara göre daha hızlı yayılıyor ve bu, kısmen azalmış nüfus koruyucu bağışıklığına bağlanıyor. İngiliz çocuk doktoru Adam Finn, “Science Media Centre”a yaptığı açıklamada, bu virüs türünün mevcut savunma mekanizmalarını kısmen atlatacak kadar “yeterince yeni” olduğunu söyledi.
Uluslararası veriler, ayrıca, Subklade K’nın mevcut aşı suşlarına kıyasla belirgin genetik sapmalar gösterdiğini ortaya koyuyor. Bu durum, enfeksiyonlara karşı etkinliği etkilese de, şu anki verilere göre ağır hastalık seyrine karşı korumayı önemli ölçüde azaltmıyor. İngiltere’de yapılan son analizlere göre aşılama, yetişkinlerde hastaneye yatışları %40’a varan oranda, çocuklarda ise %75’e varan oranda azalttı.
Avusturya’daki grip sezonunun, AGES (Avusturya Sağlık ve Gıda Güvenliği Kurumu) verilerine göre, 40. takvim haftasında, yani tipik yıllara göre birkaç hafta erken başladığı bildirildi. Vaka sayıları şu anda düşük ile orta seviye arasında seyrediyor, ancak Aralık ve Ocak aylarında belirgin bir artış bekleniyor. Yetkililer, özellikle çocuklar arasındaki yayılımı dikkatle izliyor, çünkü bu grup genellikle mevsimsel başlangıcı tetikliyor.
Somut H3N2-K vaka sayıları haftalık olarak güncelleniyor, ancak şimdiye kadar olağandışı güçlü bir artış gözlemlenmedi. Yine de, Subklade K’nın daha geniş çapta ortaya çıkması durumunda çocuklar, yaşlılar, kronik hastalığı olanlar ve hamileler özellikle risk altında kabul ediliyor.
AGES da erken aşı korumasının önemini vurguluyor. Virüsteki genetik değişikliklere rağmen, uzmanlar aşının ağır hastalık seyrini güvenilir bir şekilde azaltmaya devam edeceğini düşünüyor. Ek olarak, özellikle bakım evleri ve hastanelerde hijyen önlemlerinin artırılması tavsiye ediliyor. Antiviral ilaçlar da, özellikle risk altındaki hastalar için önemli bir araç olmaya devam ediyor.
Sezonun nihayetinde ne kadar ağır geçeceği ise şu anda tam olarak değerlendirilemiyor. Uzmanlar yıllardır, influenza’nın gerçek dinamiklerinin ancak kış aylarının ilerleyen sürecinde ortaya çıktığına dikkat çekiyor. Gabriel de Süddeutsche Zeitung’a yaptığı açıklamada, sezonun şiddetinin ancak geriye dönük olarak değerlendirilebileceğini vurguladı.